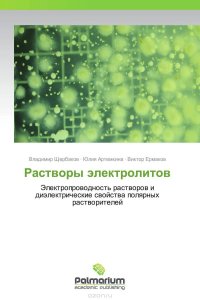

18+
На сайте представлено только описание и выходные данные книги «Растворы электролитов Юлия Артемкина und Виктор Ермаков, Владимир Щербаков». Сайт не является распространителем книги. Сайт не предоставляет возможности купить, читать онлайн или скачать бесплатно книгу «Растворы электролитов Юлия Артемкина und Виктор Ермаков, Владимир Щербаков». Сайт предназначен для лиц старше 18 лет. Если вам не исполнилось 18 лет - незамедлительно покиньте сайт. Оставаясь на сайте вы подтверждаете, что вам исполнилось 18 лет.
Незаконное потребление наркотических средств, психотропных веществ, их аналогов причиняет вред здоровью, их незаконный оборот запрещен и влечет установленную законодательством ответственность
Для описания свойств полярных растворителей использована предельная высокочастотная (ВЧ) электропроводность (ЭП), которая представляет собой отношение абсолютной диэлектрической проницаемости к времени дипольной диэлектрической релаксации. Для водных растворов неорганических солей вместо правила Вальдена предложено уравнение, в котором константа имеет размерность концентрации. Удельная ЭП концентрированных водных растворов неорганических солей составляет некоторую долю от предельной ВЧ ЭП воды. Предложены уравнения, которые позволяют оценить удельную ЭП концентрированных водных растворов на основе координационных чисел ионов и диэлектрических свойств растворителя. При увеличении температуры удельная ЭП растворов солей возрастает прямо пропорционально величине предельной ВЧ ЭП растворителя. Эта пропорциональность наблюдается в водных, неводных и смешанных водно-органических растворителях и выполняется в области, где ЭП растворов уменьшается с ростом температуры. Проведено обобщение... Это и многое другое вы найдете в книге Растворы электролитов (Владимир Щербаков, Юлия Артемкина und Виктор Ермаков)
| Полное название книги | Юлия Артемкина und Виктор Ермаков, Владимир Щербаков Растворы электролитов |
| Тип | Книга |
| Авторы | Юлия Артемкина und Виктор Ермаков, Владимир Щербаков |
| Категории | Для техникумов и вузов, Образование и наука, Книги |
| ISBN | 9783847393566 |
| Возрастное ограничение | 18 |
| Издательство | |
| Год | 2012 |
| Название транслитом | rastvory-elektrolitov-vladimir-scherbakov-yuliya-artemkina-und-viktor-ermakov |
| Просмотров | 6 |
| Рейтинг izbe.ru | 0,0 |

Мари Мур

Брук Лин

Конкордия Антарова

Дэниел Киз

Абрахам Вергезе

Аида Синицына

Вадим Зеланд

Сергей Лукьяненко

Роберт Грин

Виктор Дашкевич

Роман Прокофьев

Пауло Коэльо